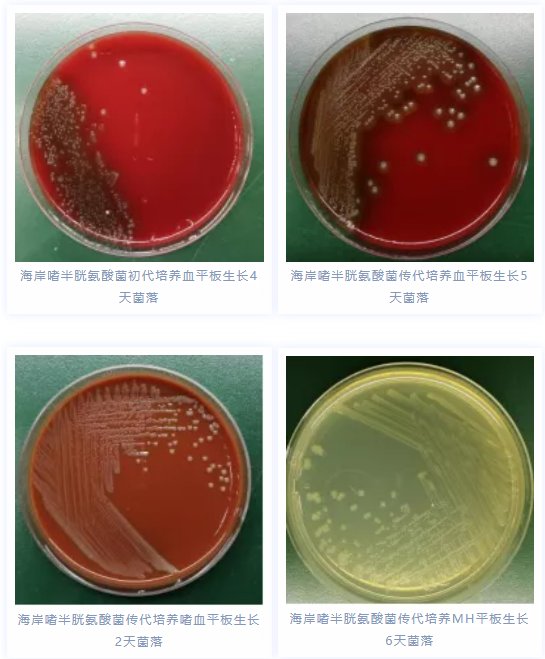
虾刺|19岁姑娘被虾刺了一下，手指红肿溃烂，20多天没愈合

19岁的小红(化名)做梦都想不到,因为被一只虾刺了一下,居然手指会红肿溃烂。

文章插图
很多家庭主妇在烧菜时多多少少都有被海鲜扎一下的经历。20多天前,小红在家处理海鲜时,不小心被一只基围虾刺破了右手手指的皮肤,她看伤口只有一点点,也就没放在心上。然而,这个肉眼几乎看不到的小伤口,居然逐渐发展为手指皮肤红肿破损溃烂,20多天都没有愈合,严重影响了她的日常工作和生活。
之后,她来到温医大附一院烧伤科就诊。经医生检查发现,小红的右手第三指皮肤红肿破溃,基底坏死伴肉芽组织增生,手指活动稍受限。通过询问病史后得知,小红20多天前曾被一只基围虾刺破手指皮肤。
为进一步明确病原体,医生对小红的伤口进行清创处理,然后取创面渗液立即送检细菌培养,并采用药物进行抗感染促愈治疗。医学检验中心微生物室在收到创面渗液标本后,立即接种培养并涂片镜检。创面渗液经24小时培养后,实验室老师发现血平板上长出了细细小小的菌落,便赶紧挑取菌落进行涂片并染色,显微镜下可以清晰看到大量的革兰阴性球杆菌。但具体属于哪个菌种,常规的鉴定方法还无法鉴定。
最后,经过专业比对,原来,小红感染的是一种十分罕见的细菌——海岸嗜半胱氨酸菌。
医院微生物室对该菌进行抗菌药物敏感性检测。根据药敏试验结果,医生采用左氧氟沙星进行抗感染治疗,经过一个多月的口服药物治疗,小红手上的伤口逐渐好转,最终治愈。

文章插图
▲ 小红的手指随着药物的应用逐渐康复
医生建议
市民在处理海鲜时应佩戴手套,被海鲜刺伤皮肤有创口未愈合时要避免接触海鲜、海水,如果不小心被海鲜扎伤应该第一时间将伤口处血液挤出,然后用清水冲洗,如果皮肤出现红肿、疼痛等症状建议及时至正规医院就诊。
【 虾刺|19岁姑娘被虾刺了一下,手指红肿溃烂,20多天没愈合】什么是海岸嗜半胱氨酸菌?
海岸嗜半胱氨酸菌(Cysteiniphilum litorale)是一种革兰阴性球杆菌,隶属于硫发菌目的苛养杆菌科。该菌最初分离于中国珠海的外伶仃岛海岸,经过文献检索与查新,该案例为首次发现海岸嗜半胱氨酸菌感染人类,相关论文发表于Indian Journal of Medical Microbiology。
文章插图
来源:掌上温州客户端
- 营养不良|可怕!19岁女生减肥到55斤,突然晕厥,送进ICU
- 功能|可怕!19岁女生减肥到55斤,突然晕厥,送进ICU
- 【提醒】23岁姑娘胃疼2周没重视,到医院却要全胃切除!这些情况要注意
- 24岁韩国姑娘因小肚腩而烦恼,坚持健身恢复身材,坦言增强了自信
- 胃镜|23岁姑娘胃疼2周没重视,到医院却要全胃切除!这些情况要注意……
- 神经衰弱|热搜第一!浙江23岁姑娘胃疼2周没重视,结果竟查出胃癌!
- 23岁姑娘胃疼2周没重视,到医院却要全胃切除!医生:这些情况要注意
- 小林|看着都疼!19岁女生摘戒指,竟把手指皮肉撕脱成“白骨”……
- 小林|看着都疼!19岁女生摘戒指,竟把手指皮肉撕脱成“白骨”
- 成根|为摘戒指,19岁女生手指皮肉撕脱成根“白骨”……隔着屏幕看疼了
